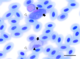

Neue internationale Initiative erforscht Wildtier-Malaria [13.12.23]
Wissenschaftler:innen der Universitäten Bielefeld und Hohenheim koordinieren das Netzwerk in Deutschland
Der weltweite Wandel des Klimas und Veränderungen in der Landnutzung sind Ursachen dafür, dass sich Krankheitserreger auch in Erdregionen ausbreiten, in denen sie zuvor nicht vorkamen. Vektor-übertragene Parasiten, zu denen beispielsweise die Erreger der Malaria gehören, beeinflussen erheblich die Anzahl an globalen Erkrankungen und gewinnen immer mehr an Bedeutung. Um diese Gruppe von Parasiten besser zu verstehen und angepasste Risikobewertungen zu entwickeln, haben sich Forschende der Universität Hohenheim mit anderen Wissenschaftler:innen weltweit zu einer neuen Initiative, dem „Wildlife Malaria Network“ (WIMANET), zusammengeschlossen. Dr. Sandrine Musa, Parasitologin an der Universität Hohenheim in Stuttgart, koordiniert das Netzwerk in Deutschland gemeinsam mit dem Bielefelder Verhaltensforscher Dr. Nayden Chakarov.
GEMEINSAME PRESSEMITTEILUNG DER UNIVERSITÄTEN BIELEFELD UND HOHENHEIM
Im Fokus stehen die weltweit verbreiteten Blutparasiten der Ordnung Haemosporida. Diese Parasiten zeichnen sich durch eine extreme Diversität aus und können mit Gesundheitsproblemen bei Menschen, Nutztieren und Wildtieren in Verbindung gebracht werden. Dr. Nayden Chakarov und Tim Maximillian Rapp haben diese Wirt-Parasit-Interaktionen am Lehrstuhl für Verhaltensforschung der Uni Bielefeld zu ihrem Forschungsschwerpunkt gemacht. An der Universität Hohenheim forscht die Arbeitsgruppe von Dr. Sandrine Musa seit rund zehn Jahren zum Thema Vogelmalaria. Das Programm wird vier Jahre lang von der „European Cooperation in Science and Technology” (COST) finanziert. „Die Zusammenarbeit zielt darauf ab, Ressourcen, Fachkenntnisse und Daten aus verschiedenen Forschungsgruppen zu vereinen, um eine effizientere Untersuchung der Parasiten bei Wildtieren auf globaler Ebene zu ermöglichen“, erklärt Chakarov.
Forschende der unterschiedlichsten Fachrichtungen, wie zum Beispiel der Vogelkunde, Säugetierkunde oder der Lehre von Amphibien und Reptilien, haben diese Parasiten über Jahrzehnte hinweg untersucht und so Einblicke in die Wechselwirkungen zwischen Wirt und Parasit sowie deren geografische Verbreitung ermöglicht. Darüber hinaus haben diese Studien die pathogenen Auswirkungen der Infektionen und deren Bedeutung für den Naturschutz von Wildtieren untersucht. „In den vergangenen Jahren haben Forschende ihren Fokus erweitert, um auch die Überträger, so genannte Vektoren, dieser Parasiten einzubeziehen, und haben genetische Techniken entwickelt, um die Identifikation der Parasiten zu erleichtern und komplexere Sachverhalte zu entschlüsseln“, sagt Musa.
Hauptziele des Netzwerks
Durch die Koordination und gemeinsame Forschungsbemühungen strebt WIMANET danach, groß angelegte kollaborative Forschungsinitiativen zu erleichtern, um lokale und regionale Grenzen zu überschreiten. Die COST-Maßnahme WIMANET verfolgt dabei folgende Hauptziele:
- Eine gemeinsame Forschungsagenda, die Forschende zur Zusammenarbeit und Wissensaustausch ermutigen soll. Durch die gemeinsame Arbeit hofft das Netzwerk, kritische Fragen im Zusammenhang mit vektorübertragenen Parasiten auf globaler Ebene zu klären.
- Eine interdisziplinäre Zusammenarbeit. Gefördert werden soll ein interdisziplinärer Ansatz, bei dem Expert*innen verschiedener Fachbereiche zusammengebracht werden. Diese vielfältigen Kooperationen sollen zu einem umfassenderen Verständnis des Wirt-Vektor-Parasit-Systems der Haemosporida führen.
- Die Unterstützung von Forschenden. Forschende jeglicher Herkunft sollen unterstützt werden, indem ihnen Möglichkeiten zur Ausbildung und Zusammenarbeit geboten werden. Dieser inklusive Ansatz zielt darauf ab, die Expertise des Netzwerks zu erweitern und seine kollektive Wirkung zu stärken.
- Die Einbeziehung der Interessengruppen. Ziel ist es aktiv mit Interessengruppen, Entscheidungsträger*innen und der Öffentlichkeit zusammenzuarbeiten, um den Wissenstransfer zu erleichtern. Durch die Sensibilisierung für vektorübertragene Parasiten und ihre Auswirkungen strebt die Initiative an, Unterstützung für ihre Forschungsbemühungen zu gewinnen.
„Durch die Vereinigung von Forschenden und Institutionen aus aller Welt verspricht WIMANET, unser Verständnis von Blutparasiten bei Wildtieren zu vertiefen. Es sollen effektive Strategien entwickelt werden, um die Herausforderungen zu bewältigen, denen wir uns mit Malariaparasiten bei Wildtieren in einer sich verändernden Welt gegenübersehen“, sagt Chakarov.
Weitere Informationen
Website der COST-Maßnahme „Wildlife Malaria Network“ (WIMANET)
Leucocytozoon toddi aus Echsenhabicht (Accipiter francesiae, Accipitridae) beprobt im Maromizaha Regenwald, Madagaskar. Makrogametozyt (oben) und Mikrogametozyt (unten) in spindelförmigen Wirtszellen. Schwarze Pfeilspitze: Zellkern der Wirtszelle, weiße Pfeilspitze: Zytoplasma der Wirtszelle, schwarzer Pfeil: Zellkörper des Parasiten. Giemsa gefärbter Blutausstrich. Maßstabsbalken = 10 µm.
Bildquelle: Universität Hohenheim / Sandrine Musa
Kontakt für Medien:
Dr. Sandrine Musa, Universität Hohenheim, Fachgebiet Parasitologie
T +49 711 459 23067, E Sandrine.Musa@uni-hohenheim.de
Dr. Nayden Chakarov, Universität Bielefeld, Lehrstuhl für Verhaltensforschung
T +49 521 106-2620, E nayden.chakarov@uni-bielefeld.de